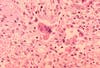

Two young children sat together on the floor, laughing. The 2 year-old didn’t know that his coughing, sneezing playmate was spewing invisible viral particles into the air between them. He breathed deeply, drawing the microbes into his respiratory tract where they would settle, their presence unknown until white spots appeared in the boy’s mouth and his face flushed with fever. Soon, an angry red rash appears as his immune system tried desperately to clear the viral particles and keep them from invading his lungs, kidneys and brain.
The scenario isn’t a trailer for a Hollywood movie about a new killer strain of flu. Instead, it is a realistic depiction of how an unvaccinated child might pick up the measles from an infected friend. Measles, or rubeola, is a highly contagious disease and someone who hasn’t been vaccinated has a 99 percent chance of picking it up if exposed to a coughing, sneezing individual with the virus.
The measles virus is called a paramyxovirus and invades lymphatic tissue (including lymph nodes) and blood. Normally, the virus is cleared by an individual's T-cells, which are immune cells, but serious complications can lead to permanent brain damage or death. In developing countries, more than 15 percent of children infected with measles die of the disease or complications from the infection.
Find out what's happening in Edinafor free with the latest updates from Patch.
Worldwide, the measles virus is a deadly threat, but an avoidable one. Ten years ago, measles was the fifth leading killer of children, but according to the World Health Organization, measles vaccination resulted in a 78 percent drop in measles deaths between 2000 and 2008 worldwide. Unfortunately, they also say it "remains one of the leading causes of death among young children globally, despite the availability of a safe and effective vaccine. An estimated 164,000 people died from measles in 2008—mostly children under the age of five."
Here in Minnesota, we consider ourselves safe from the disease, which mostly kills children in developing countries. However, in August, Minnesota saw three cases of measles which began in an unvaccinated child, and spread to a second unvaccinated child and an adult who did not have immunity. The Star Tribune reported that one of the children—infected during a family trip to Kenya—nearly died.
Find out what's happening in Edinafor free with the latest updates from Patch.
Last spring, in a separate outbreak in Minnesota, at least 20 individuals came down with the measles.
Vaccination can protect most people from catching the measles virus and children can be protected from the potentially deadly disease by the MMR (Measles, Mumps, Rubella) vaccine, which is typically first given to infants around 12 months of age.
According to Gayle Kelly, executive director of the Minnesota Head Start Association, almost 60 percent of Minnesota children ages 24 to 35 months have not had all recommended vaccines. This leaves them susceptible to diseases like measles and whooping cough, which continue to show up in the United States with the potential to sicken and even kill unvaccinated children.
Especially vulnerable are infants and children too young to have recieved all their vaccines, who may be exposed to the diseases by unvaccinated siblings and playmates.
My generation has been lucky enough to live in an era where most of the population is vaccinated against diseases like measles, polio, diphtheria and whooping cough, which used to kill children on a regular basis, even in my parents’ generation. I don’t know anyone my age who has lost a child to these preventable diseases and hope people’s unwarranted distrust of vaccination doesn’t thrust us back into an era where infants can’t leave the house for fear of coming into contact with an unvaccinated child carrying a deadly disease.
Clinics in Edina, like Southdale Pediatricians, all offer vaccinations for children. Children without health insurance, or needing assistance can get free or low-cost vaccines through The Minnesota Vaccines for Children Program (MnVFC.)
If you will be traveling to Europe or certain parts of Africa where measles is endemic (constantly present), the Minnesota Department of Health recommends the MMR vaccine be given to infants earlier, between 6 and 12 months old. Vaccination may also be recommended for some susceptible adults.